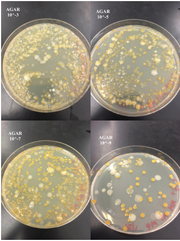

Uploads by Megan Piccirillo
From OpenWetWare
Jump to navigationJump to search
This special page shows all uploaded files.
| Date | Name | Thumbnail | Size | Description |
|---|---|---|---|---|
| 01:20, 26 March 2015 | SurvivalZEBRACAF210.jpg (file) |  |
59 KB | |
| 01:20, 26 March 2015 | Zebra210fish210.jpg (file) |  |
77 KB | |
| 13:02, 10 March 2015 | ZfishDevchart210.jpg (file) |  |
954 KB | |
| 12:51, 10 March 2015 | Controlzfish210.jpg (file) |  |
1.49 MB | |
| 12:39, 10 March 2015 | ZfishEmbryoCaffDay2.jpg (file) |  |
226 KB | |
| 12:35, 10 March 2015 | MOLDYzfish210.jpg (file) |  |
1.16 MB | |
| 12:15, 27 February 2015 | PCR210picc.jpg (file) |  |
356 KB | |
| 12:29, 20 February 2015 | FOODweb2106.jpg (file) |  |
58 KB | |
| 17:30, 19 February 2015 | Tableinvert210.jpg (file) |  |
55 KB | |
| 17:25, 19 February 2015 | Tableinvert210brates.jpg (file) |  |
56 KB | |
| 04:50, 12 February 2015 | SpecimenPics210.jpg (file) |  |
173 KB | |
| 04:30, 12 February 2015 | Tablefunplan210.jpg (file) |  |
64 KB | |
| 14:19, 5 February 2015 | TableBacBIO210.jpg (file) |  |
53 KB | |
| 14:04, 5 February 2015 | TableAU210.jpg (file) |  |
35 KB | |
| 13:51, 5 February 2015 | TETplates.jpg (file) |  |
242 KB | |
| 13:50, 5 February 2015 | AGARplates.jpg (file) | |
252 KB | |
| 13:43, 5 February 2015 | Jars.jpg (file) |  |
144 KB | |
| 18:45, 28 January 2015 | Image clopidium.jpg (file) |  |
1.08 MB | |
| 18:44, 28 January 2015 | Image gonium.jpg (file) |  |
131 KB | |
| 18:43, 28 January 2015 | Image livepaparme.jpg (file) |  |
1.31 MB | |
| 18:38, 28 January 2015 | Image abc.jpg (file) |  |
127 KB | |
| 14:49, 28 January 2015 | Image 1091.jpg (file) |  |
1.99 MB | |
| 14:47, 28 January 2015 | Image 1090.jpg (file) |  |
1.63 MB | |
| 14:45, 28 January 2015 | IMG 1090.jpg (file) |  |
1.63 MB | |
| 14:37, 28 January 2015 | Image 1083.jpg (file) |  |
1.25 MB | |
| 14:35, 28 January 2015 | IMG 1083.jpg (file) |  |
1.25 MB | |
| 14:22, 28 January 2015 | Image 1084.jpg (file) |  |
1.37 MB | |
| 14:18, 28 January 2015 | IMG 1084.jpg (file) |  |
1.37 MB | |
| 22:33, 26 January 2015 | IMG 1133.jpg (file) |  |
4.96 MB | |
| 22:25, 26 January 2015 | IMG 1133.JPG (file) |  |
4.96 MB | |
| 22:24, 26 January 2015 | IMG 1129.jpg (file) |  |
4.91 MB | |
| 22:16, 26 January 2015 | IMG 1131.jpg (file) |  |
5.19 MB |